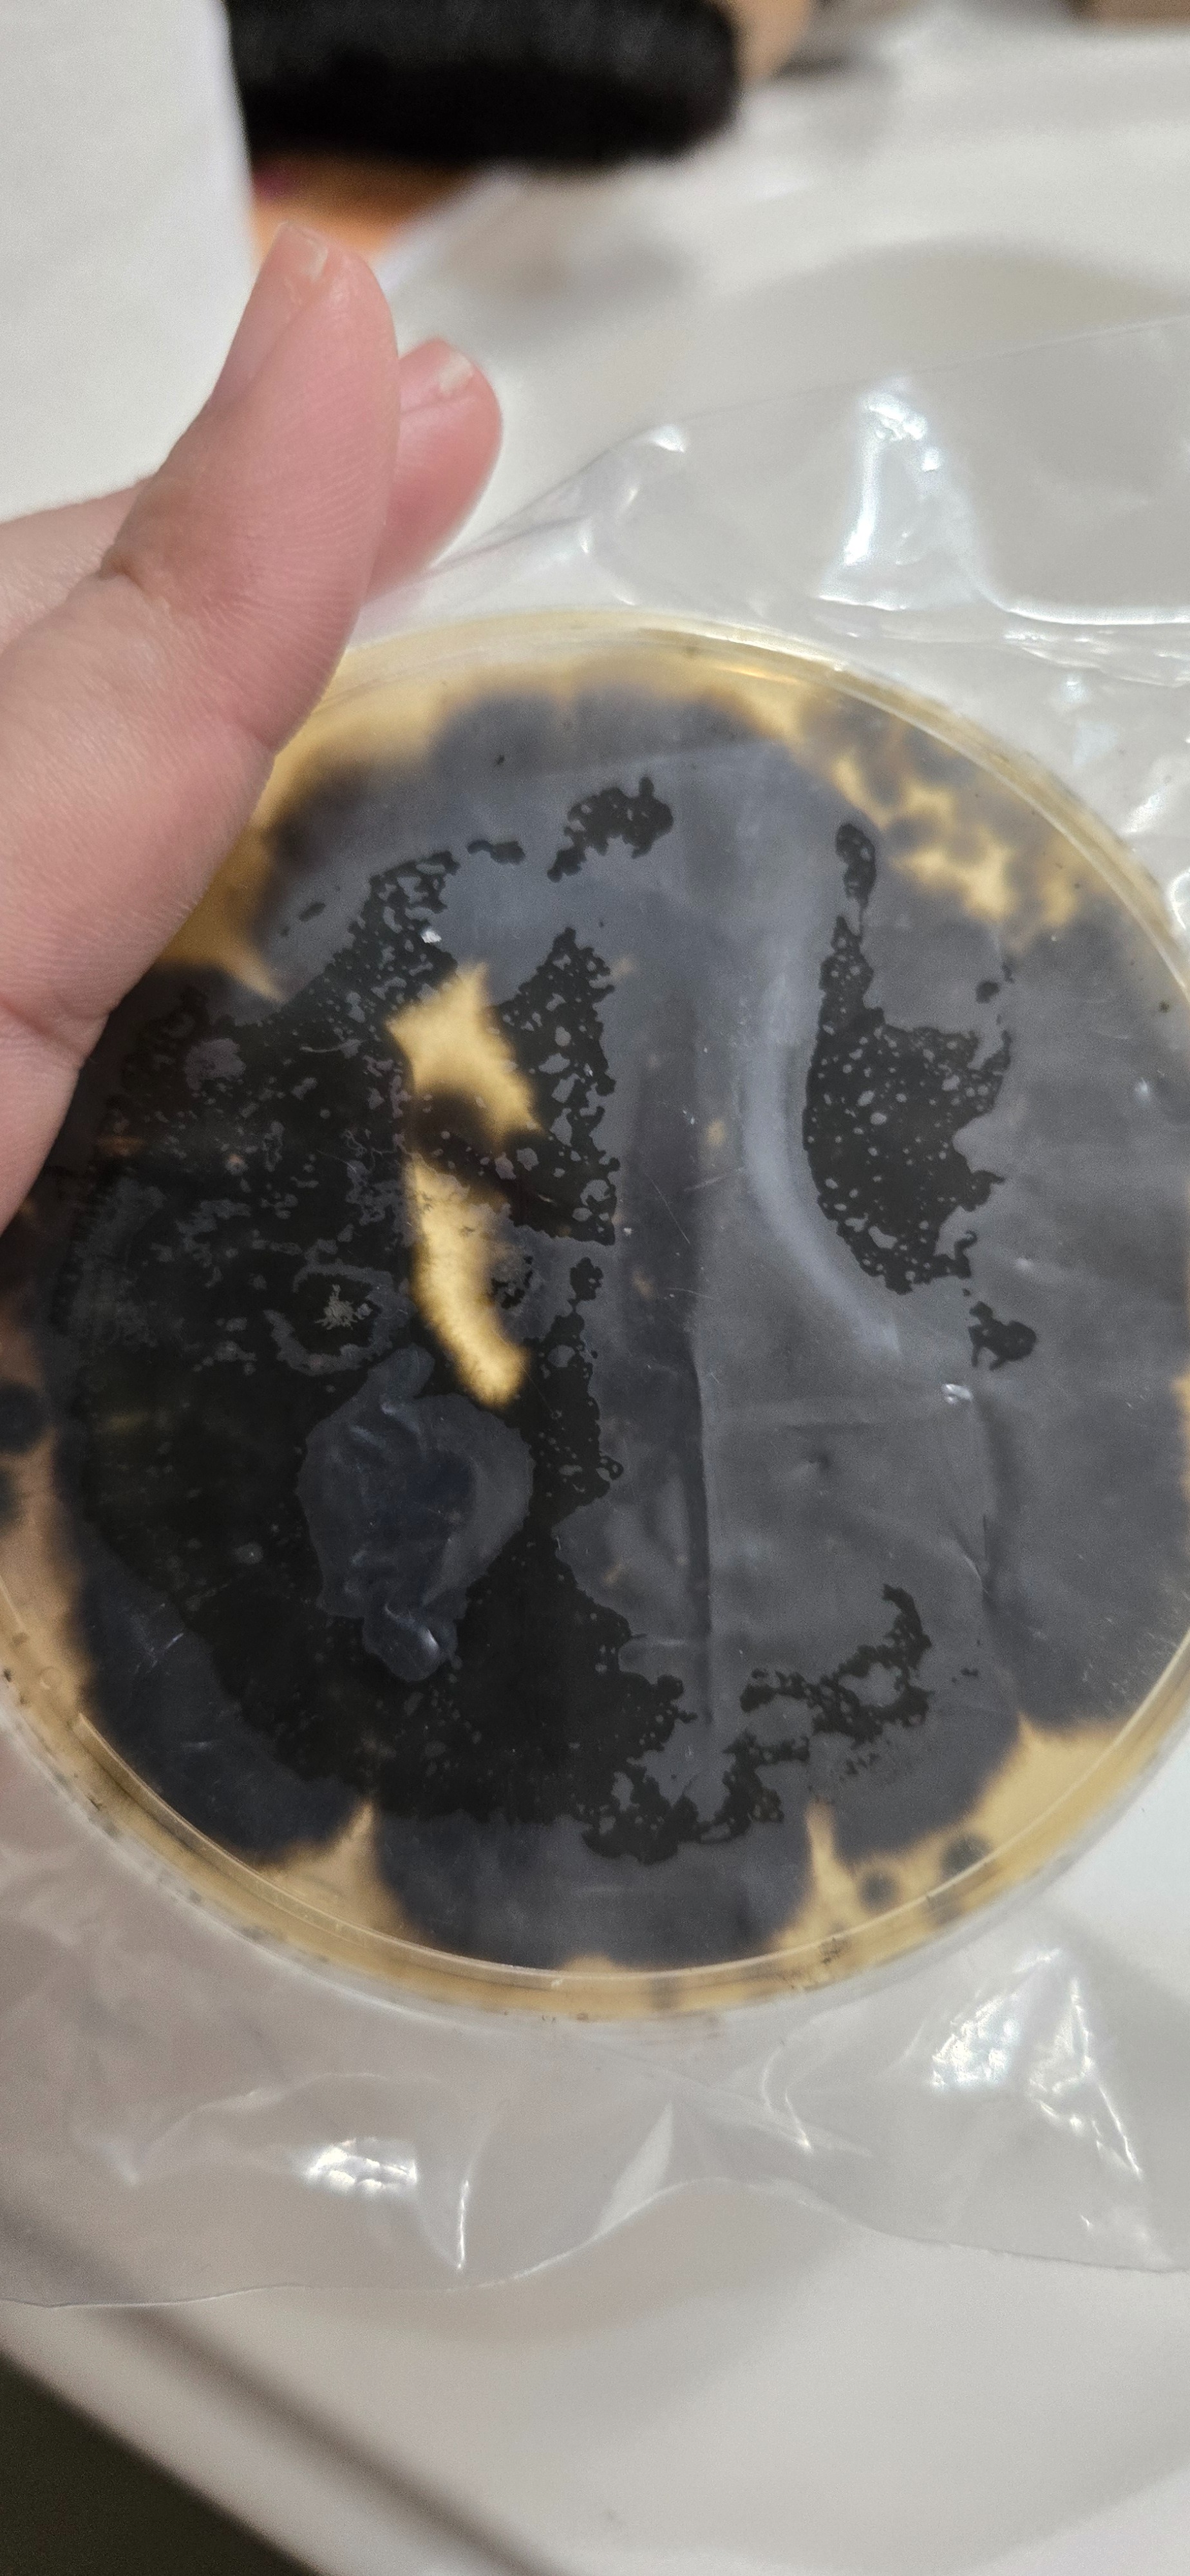

- B
- A
- N
My name is Liz, and I’m reaching out for help for my family during an extremely difficult time. We live in an apartment in Winter Haven, where we recently discovered mold growing in several areas of our home. Everything started when my daughter Valentina began having persistent allergies, congestion, and irritation that we couldn’t explain. After investigating, we found humidity and mold in the walls, bathrooms, windows, and cabinets. Despite sending photos, reports, and documentation, the apartment administration has been very slow to address the situation. Our biggest concern is Valentina’s health—especially because she has an upcoming surgery, and we need her to be in a clean and safe environment before her recovery. We want to move for our daughter’s health and because of the lack of timely response from the administration. But we are facing a major challenge: we do not have the funds for a new deposit, first month’s rent, or to replace items damaged by humidity. As a family, I am a special education teacher and my husband works long overnight shifts. We have two children and two dogs. We work hard every day, but right now we need help to get our daughter out of an environment that may continue affecting her health. Funds will be used for a security deposit and first month’s rent, replacing mattresses and items affected by humidity, moving expenses, and essential items for our kids. Most importantly, we want to provide a safe environment for Valentina’s recovery after surgery. Any help—even the smallest amount—means the world to us. And if you cannot donate, sharing this campaign helps tremendously. Thank you from the bottom of our hearts for reading our story and for supporting us during this difficult moment, especially during the holiday season.
Hola, mi nombre es Liz.
Soy mamá de dos niños, y uno de ellos tiene alergia al moho.
Durante meses hemos estado viviendo en un apartamento con humedad excesiva y áreas visibles de moho. Mi hija ha estado enferma repetidamente, y aunque finalmente logramos que la administración inspeccionara la unidad, nunca nos entregaron un reporte ni confirmación escrita de los resultados.
Ahora, además de esta situación, mi hija será operada en diciembre — lo que hace todavía más urgente poder mudarnos a un ambiente seguro donde ella pueda recuperarse sin riesgo adicional.
La administración nos dio dos opciones:
✔️ mudarnos a otra unidad dentro del complejo,
o
✔️ cancelar el contrato y salir sin penalidad.
También nos informaron que para reparar la unidad donde vivimos tendríamos que desalojar temporalmente y pagar un hotel.
Pero tenemos mascotas y no tenemos dónde llevarlos ni cómo cubrir un hospedaje pet-friendly, además de que sería un ambiente estresante para mi hija antes de su cirugía.
Agradecemos que nos permitan salir sin penalidad, pero esta decisión llegó de forma inesperada y sin el respaldo económico necesario para mudarnos de inmediato, reemplazar pertenencias afectadas por humedad/moho y conseguir un hogar seguro para que mi hija pueda sanar.
Mi deseo como mamá siempre ha sido darle a mis hijos un espacio saludable — donde mi hija no siga enfermándose, donde pueda recuperarse de su cirugía y donde podamos vivir sin el miedo constante de regresar a un lugar con moho.
Lo que pedimos no es lujo, sino salud y estabilidad.
Esta ayuda se utilizará para:
depósito y gastos iniciales de renta
reemplazar artículos afectados por humedad/moho
mudanza y limpieza
citas médicas de seguimiento después de la cirugía y si se confirma exposición
Nunca pensé tener que pedir ayuda, pero lo hago porque mi hija necesita salir de este ambiente antes de su operación, y no tenemos los medios para hacerlo solos mientras cuidamos su salud y nuestras mascotas.
Si puedes donar o compartir nuestra campaña, estarías ayudándonos a salir de un hogar con humedad y moho y permitiendo que mis hijos —especialmente mi hija en proceso de cirugía— puedan vivir y sanar en un lugar seguro.
Desde mi corazón,
gracias por leer, donar o compartir
Cuando logremos mudarnos, compartiré fotos de nuestro nuevo hogar para que puedan ver cómo su ayuda realmente marcó una diferencia en nuestra vida.